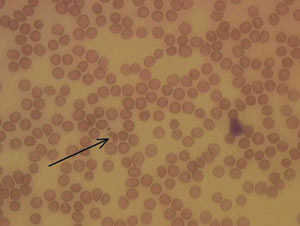
Figur 2  I dette blodutstryket er en schistocytt med typisk utseende markert med pil. Schistocytter kan forekomme n&aring;r&hellip;

En jente ble født i juli 1999, to uker før ultralydterminen. Det tilkom spontan vannavgang 38 timer før riene begynte. Riesvekkelse og protrahert fødselsforløp gjorde vakuumforløsning nødvendig. Bortsett fra et par cystitter var svangerskapet ukomplisert. Foreldrene var norske, ubeslektede og friske. I timene etter fødselen så man at barnet var blek i huden og cyanotisk distalt på ekstremitetene. Blodprøver viste trombocytter 40 x 10⁹/l, hemoglobin 16,1 g/dl, leukocytter 36 x 10⁹/l, totalbilirubin 270 µmol/l og CRP 2. Ved nærmere undersøkelse ni timer etter fødselen fant man spredte petekkier på truncus og blåmerker på underekstremitetene. Man startet lysbehandling og sepsisbehandling med intravenøs antibiotika. Jenta utviklet i løpet av de første levedagene alvorlig anemi i tillegg til sin trombocytopeni. Barnet hadde makroskopisk hematuri og lett kreatininstigning den første leveuken. Retikulocytter og laktatdehydrogenase var elevert ved én ukes alder. Barnet fikk flere infusjoner med blod og normalt, humant immunglobulin (Octaplas) de første to ukene. Direkte Coombs prøve var negativ. Blodprøver og urin normaliserte seg gradvis, og jenta ble utskrevet etter tre uker. Ultralydundersøkelse av hodet, abdomen og nyrene viste ingen patologiske forandringer.
Vi stod her overfor en sammensatt problemstilling med trombocytopeni, anemi, mild nyresvikt og hyperbilirubinemi. Hyperbilirubinemi det første levedøgnet er patologisk, og kjerneicterus er en fryktet komplikasjon. Lysbehandling, som i vår kasuistikk, er den mest brukte behandlingen mot hyperbilirubinemi, mens utskiftningstransfusjon forbeholdes de alvorligste tilfellene. Hyperbilirubinemi er hos det store flertallet av nyfødte en normalfysiologisk hendelse, men kan også skyldes hemolytiske tilstander eller infeksjoner. Det ble utredet med henblikk på rhesus- og ABO-uforlikelighet og sfærocytose, men det ga ingen forklaring på anemien og økningen i laktatdehydrogenase, retikulocytter og bilirubinverdiene. Det kunne ikke påvises antistoffer mot erytrocytter eller trombocytter. Økt tidsintervall mellom vannavgang og rieaktivitet disponerer for perinatale infeksjoner. Prøver fra øyesekret, hals, feces, urin og blod viste ingen oppvekst av patogene mikrober, og omfattende serologiske prøver fra mor og barn ga ingen holdepunkter for aktive infeksjoner. I blodutstryk så man etter fragmenterte erytrocytter og såkalte hjelmceller som ved hemolytisk-uremisk syndrom, men man fant ikke tegn til slike. Mistanke om idiopatisk trombocytopenisk purpura var årsaken til behandling med normalt, humant immunglobulin. Ved denne tilstanden skal imidlertid blodprøver vise trombocytopeni som eneste abnormitet.
Barnet ble innlagt på ny én uke etter utskrivning med moderat anemi og mild trombocytopeni. Hun mottok blodtransfusjon og det ble rask bedring. Hun hadde normal vekst og psykomotorisk utvikling i månedene fremover. Ni måneder gammel ble jenta brakt til sykehus igjen etter to dager med nesetetthet og febrilia. Ved innleggelse fant man multiple petekkier og icterus. Allmenntilstanden var god. Hun hadde en uttalt trombocytopeni og hemolytisk anemi med redusert hemoglobin, redusert haptoglobin, elevert laktatdehydrogenase, elevert bilirubin, retikulocytose og mikrohematuri. Blodutstryk viste en del kjerneholdige røde blodceller, erytroblaster og schistocytter (fig 1, fig 2) samt god variabilitet med hensyn til lymfocytter og nøytrofile granulocytter. Direkte og indirekte Coombs prøve var negativ. Både direkte og indirekte trombotest var negativ. Det kunne ikke påvises antistoffer mot erytrocytter og trombocytter, og alle immunologiske prøver var negative. Jenta fikk infusjoner med normalt, humant immunglobulin og hun ble bektraktelig bedre i løpet av en uke. Seks uker etter utskrivning utviklet jenta i forbindelse med en streptokokkfaryngitt igjen trombocytopeni, men ingen behandlingsintervensjon var nødvendig. Blodprøver de påfølgende månedene viste hele tiden en moderat trombocytopeni. 17 måneder gammel fikk hun vannkopper og utviklet en alvorlig trombocytopeni som ble behandlet med ferskfrosset plasma (Octaplas).

Evans syndrom var blant differensialdiagnosene som ble diskutert. Denne tilstanden skyldes autoantistoffer rettet mot erytrocytter, trombocytter og eventuelt nøytrofile granulocytter. Utredningen ga imidlertid ingen holdepunkter for autoimmun genese. Trombocytopeni og anemi kan også ses ved leukemi, beinmargssykdommer, sepsis, bindevevssykdommer og som en bivirkning til medikamentell behandling.
Blodprøver ble sendt til koagulasjonslaboratoriet ved Rikshospitalet uten at koagulopati kunne påvises. Beinmargsutstryk viste ingen tegn til patologi. I november 2000 ble plasmaprøver sendt til Hematologisk sentrallaboratorium, Inselspital i Bern, Sveits. En forskningsgruppe der hadde påvist at mangel på von Willebrands faktor spaltende protease-13 (A disintegrin and metalloprotease with thrombospondin type 1 domains, ADAMTS-13) kunne forårsake trombotisk trombocytopenisk purpura. Svaret fra Sveits viste komplett mangel på ADAMTS-13. Det kunne ikke påvises antistoffer mot dette. Enzymaktivitet hos begge foreldrene og pasientens yngre søster ble senere målt til omtrent 50 % av det normale. Man stilte således diagnosen ADAMTS-13-mangel og hereditær trombotisk trombocytopenisk purpura. Tilstanden går også under navnet Upshaw-Shulmans syndrom. Behandling i form av regelmessige infusjoner med ferskfrosset plasma ble startet opp. Over et par måneder titrerte man seg frem til at infusjoner annenhver uke var tilstrekkelig for å forebygge trombocytopeni og nye episoder med trombotisk trombocytopenisk purpura. Jenta har siden kun hatt enkelte episoder med trombocytopeni i forbindelse med infeksjoner og flyreise.
Diskusjon
Trombotisk trombocytopenisk purpura (TTP) er hyppigst hos kvinner og voksne, og forekommer med insidens 3,7 tilfeller per 1 000 000 innbyggere per år i USA (1). Tilstanden ble først beskrevet av dr. Eli Moschcowitz i 1924 og karakteriseres av pentaden mikroangiopatisk hemolytisk anemi, trombocytopeni, feber, akutt nyresvikt og nevrologiske symptomer. Introduksjonen av plasmautskiftning og infusjoner med ferskfrosset plasma reduserte mortaliteten fra over 90 % til rundt 10 – 20 % (1). Andre behandlingsmodaliteter beskrevet med varierende effekt er glukokortikoider, platehemmere, vinkristin, splenektomi og intravenøs immunglobulintilførsel. Like viktig som korrekt terapi er det å unngå trombocyttransfusjoner. Flere rapporter indikerer at trombocyttilførsel fører til rask klinisk forverring, og dødsfall er beskrevet (2). Diagnosen trombotisk trombocytopenisk purpura kan være vanskelig å stille, siden det kliniske bildet kan variere og pasientgruppen er heterogen. Tilstanden er assosiert med kreftsykdommer, kjemoterapi, beinmargstransplantasjon, graviditet, bakterielle infeksjoner, hivinfeksjon og vaskulære lidelser (3). Etanolinntak er angitt som utløsende faktor for akutt trombotisk trombocytopenisk purpura hos en pasient med ADAMTS-13-mangel (4). Vår pasient hadde ingen nevrologiske utfall, men dette er beskrevet hos andre pasienter med denne mangelen (3).
Hemolytisk uremisk syndrom er beslektet med trombotisk trombocytopenisk purpura og kjennetegnes av den samme pentaden. Sykdommen opptrer hyppigst hos barn. Utvikling av den er ofte knyttet til infeksjoner med bakteriene Escherichia coli, Shigella og Salmonella og forutgås derfor ofte av en gastroenteritt. Det er spesielt verotoksinproduserende E coli 0157:H7 som assosieres med hemolytisk uremisk syndrom (5).
De siste årene har man påvist tilfeller av trombotisk trombocytopenisk purpura som skyldes manglende aktivitet av ADAMTS-13. Von Willebrands faktor er et multimerprotein produsert i endotelceller og megakaryocytter. Von Willebrands faktor-multimere skilles ut i sirkulasjonen og spaltes i mindre enheter av ADAMTS-13. Når ADAMTS-13-aktiviteten er fraværende eller tilstrekkelig redusert, opptrer uvanlig store von Willebrands faktor-multimere i plasma og bidrar til økt trombocyttaggregasjon. Under episoder med akutt trombotisk trombocytopenisk purpura forbrukes von Willebrands faktor-multimere og forsvinner fra plasma. Infeksjoner, graviditet og kjemoterapi bidrar til økt utskillelse av von Willebrands faktor og forklarer noe av assosiasjonen med utviklingen av trombotisk trombocytopenisk purpura (3). ADAMTS-13-aktivitet så lav som 5 – 10 % av det normale ser ut til å være tilstrekkelig for å forebygge mikrovaskulær trombocyttaggregasjon (6). Aktivitet under 5 % av normalverdien er assosiert med utvikling av trombotisk trombocytopenisk purpura, og kan være ervervet eller medfødt. Den medfødte varianten ser ut til å følge autosomalt recessiv arvegang, og flere mutasjoner av ADAMTS-13-genet er beskrevet. Blant pasienter med trombotisk trombocytopenisk purpura er det identifisert homozygote og heterozygote bærertilstander av muterte alleler (5). Vår pasient er homozygot for en mutasjon. Den ervervede formen skyldes inhiberende autoantistoffer mot ADAMTS-13 (7). Pasienter med hemolytisk uremisk syndrom har ikke mangel på ADAMTS-13 (8).
Årsaken til at vår pasient initialt responderte på normalt, humant immunglobulin og senere på ferskfrosset plasma, er at disse produktene inneholder ADAMTS-13. Faktor VIII-konsentrat fremstilt av ferskfrosset plasma benyttes ved hemofili A og von Willebrands sykdom, men er også blitt rapportert å være effektivt ved ADAMTS-13-mangel (9, 10). Rekombinant ADAMTS-13 til kommersiell bruk er ikke tilgjengelig per i dag. Selv om den biologiske halveringstiden til ADAMTS-13 er to til fire dager, er profylaktiske plasmainfusjoner annenhver uke nok til å forhindre trombocytopeni og residiv av trombotisk trombocytopenisk purpura hos vår pasient. Fravær av autoantistoffer mot ADAMTS-13 forklarer effekten av relativt små plasmainfusjoner. I dag er plasmautskiftning, infusjoner med ferskfrosset plasma og eventuelt glukokortikoider førstevalg ved akutt trombotisk trombocytopenisk purpura. Pasienter med denne tilstanden som følge av medfødt ADAMTS-13-mangel responderer meget godt på infusjoner med ferskfrosset plasma som monoterapi. Plasmautskiftning og andre behandlingsmodaliteter er som regel ikke nødvendig i disse tilfellene. Det knytter seg en rekke spørsmål til vår pasients fremtid, spesielt til hva som skjer når hun kommer i puberteten og senere eventuelt blir gravid. Inntil videre er hun et friskt og aktivt barn som avlegger barneavdelingen i Ålesund et besøk annenhver uke.
Forfatterne ønsker å takke Robert Brudevold og Marius Kurås Skram for konstruktive innspill i forbindelse med utforming av artikkelen.
Oppgitte interessekonflikter: Ingen
- 1.
Studt JD, Kremer Hovinga JA, Alberio L et al. Von Willebrand factor-cleaving protease (ADAMTS-13) activity in thrombotic microangiopathies: diagnostic experience 2001/2002 of a single research laboratory. Swiss Med Wkly 2003; 133: 325 – 32.
- 2.
Kwaan HC, Soff GA. Management of thrombotic thrombocytopenic purpura and hemolytic uremic syndrome. Semin Hematol 1997; 2: 159 – 66.
- 3.
Häberle J, Kehrel B, Ritter J et al. New strategies in diagnosis and treatment of thrombotic thrombocytopenic purpura: case report and review. Eur J Pediatr 1999; 158: 883 – 7.
- 4.
Kentouche K, Budde U, Furlan M et al. Remission of thrombotic thrombocytopenic purpura in a patient with compound heterozygous deficiency of von Willebrand factor-cleaving protease by infusion of solvent/detergent plasma. Acta Paediatr 2002; 91: 1056 – 9.
- 5.
Lissauer T, Clayden G. Illustrated textbook of pediatrics. London: Mosby, 2001: 267 – 8.
- 6.
Kinoshita S, Yoshioka A, Park YD et al. Upshaw-Schulman syndrome revisited: A concept of congenital thrombotic thrombocypenic purpura. Int J Hematol 2001; 74: 101 – 8.
- 7.
Tsai HM, Lian ECH. Antibodies to von Willebrand factor-cleaving protease in acute thrombotic thrombocytopenic purpura. N Engl J Med 1998; 339: 1585 – 94.
- 8.
Furlan M, Robles R, Galbusera M et al. Von Willebrand factor-cleaving protease in thrombotic thrombocytopenic purpura and the hemolytic-uremic syndrome. N Engl J Med 1998; 339: 1578 – 84.
- 9.
Lester WA, Williams MD, Allford SL et al. Succesful treatment of congenital thrombotic thrombocytopenic purpura using the intermediate purity factor VIII concentrate BPL 8Y. Br J Haematol 2002; 119: 176 – 9.
- 10.
Allford SL, Harrison P, Lawrie AS et al. Von Willebrand factor-cleaving protease activity in congenital thrombotic thrombocytopenic purpura. Br J Haematol 2000; 111: 1215 – 22.